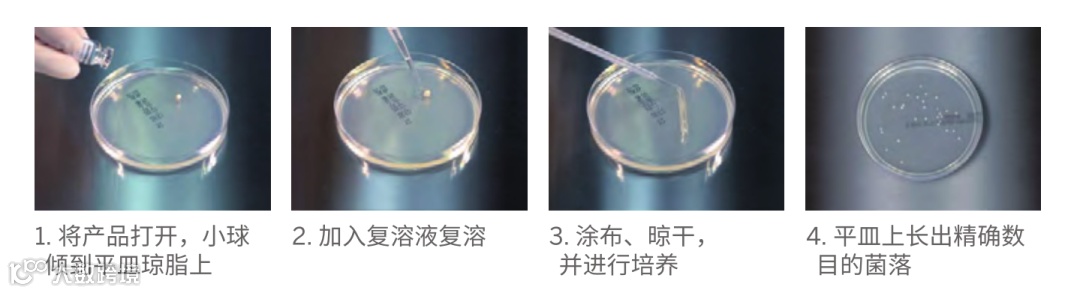

“
标准菌株是微生物检测领域的标准参照物,它贯穿于微生物检测的各个环节。
标准菌株的用处多多,你知道吗?

”
标准菌株应用最多之一的是:
而且如果把标准菌株数量精准化,
那它的应用范围将会更加广泛。
#1
抑菌/防腐剂效能测试
#2
无菌检查
#3
实验室消毒与灭菌效果的评价指示菌
#4
实验室试剂和培养基等的性能测试
目前常用的菌株定量化方式
1.传统系列稀释法:标准菌株从0代干粉活化制备成标准工作菌株,再制备相对应浓度的菌悬液。此过程需要操作人员有一定的工作经验和技术要求,且活化培养的耗费时间通常较长。

2.商业定量化标准菌株:经过活化和精准定量的菌株,按要求溶解稀释之后,就能获得所需要浓度的菌悬液,比传统方法缩短1-7d。

BIOBALL


1.在中国药典2020版 9203《药品微生物实验室质量管理指导原则》中,有明确标示:可以使用商业派生菌株来进行相关的微生物实验。


2.专利的流式筛选技术生产。该专利技术可区分不同群体微生物颗粒的物理和生理状态,仅状态好(具有最大恢复率)的微生物被选择制作成Bioball定量菌株,确保了空前的精确性和最大的存活率。
通过液氮冷冻干燥和真空封口技术确保精确的菌量、最长的有效期和最大的恢复率。
Bioball是通过ISO Guide 34认证的标准物质,意味着用户可完全信赖产品的质控报告及标准菌株的可溯源性。再也不用担心被人挑战菌株的溯源数据的准确性。
3.与传统系列稀释法相比优势

Bioball 操作简单,省时省力

Bioball 菌量稳定且精确
4.目前提供超过30种菌株,可应用于制药工业、食品化妆品工业及水测试,下图为部分截图。

【1】中华人民共和国出入境检验检疫行业标准:SN/T 1538.2-2016《培养基制备指南 第2部分:培养基性能测试实用指南》.北京:中国标准出版社,2-8
【2】国家技术监督局.中华人民共和国国家标准消毒与灭菌效果的评价方法与标准:GB 15981-1995[S].北京:中国标准出版社,1995:1-3.
【3】中华人民共和国国家卫健委健康委员会卫生行业标准:WS/T 650—2019《抗菌和抑菌效果评价方法》.北京:中国标准出版社,2019:2
1
END
1















